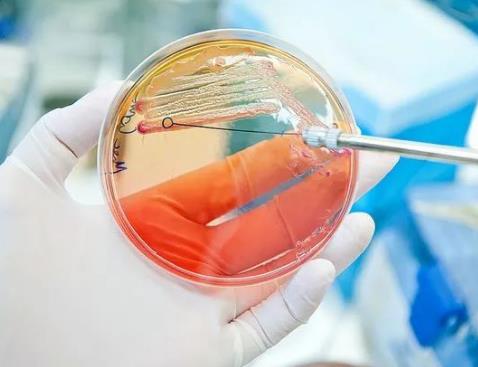

細(xì)菌耐藥性正在迅速發(fā)展,許多至關(guān)重要的藥物面臨被淘汰的風(fēng)險。因此,如果不謹(jǐn)慎使用這些藥物,災(zāi)難性的后果將等待著。
這是世界衛(wèi)生組織(WHO)在2014年4月發(fā)出的嚴(yán)厲警告,規(guī)定需要對我們?nèi)绾紊a(chǎn)、處方和使用抗菌藥物采取“重大行動”。作為回應(yīng),微生物學(xué)家正在努力研制新藥,或開發(fā)新的方法來對抗感染。其中許多替代方案處于研發(fā)階段,距離完成還有不同的距離。有哪些抗生素的替代品呢?使用疫苗可以預(yù)防而不是治愈病毒和細(xì)菌等病原體的感染,使機(jī)體對特定病原體產(chǎn)生免疫力。疫苗通過模擬感染病原體或疾病來刺激機(jī)體的反應(yīng),然后機(jī)體會在未來“記住”這些病原體或疾病。然而,它們在一定程度上受到整個群體的接種成本的限制。一些國家難以將疫苗儲存到合適的溫度,當(dāng)需要增強(qiáng)劑時,會出現(xiàn)進(jìn)一步的并發(fā)癥。
正確地使用可能意味著隨后的加強(qiáng)免疫和疫苗冷藏盡管遇到挫折,科學(xué)界的許多人認(rèn)為,疫苗在未來謹(jǐn)慎使用抗生素方面將發(fā)揮重要作用。動物和人類健康研究團(tuán)體都在大力推動研發(fā)新的和創(chuàng)新的疫苗技術(shù)和平臺。疫苗類型
疫苗是通過使用活的、死的或滅活的病原體、滅活毒素或病原體的片段來生產(chǎn)的。表中顯示了現(xiàn)代科學(xué)中一些關(guān)鍵的疫苗類型。
疫苗類型 | 作用機(jī)理 |
活的、致弱 · 重組載體 | 活的微生物只是被致弱了,限制了致病力。是免疫系統(tǒng)的好老師。一生的免疫可通過1或2劑實(shí)現(xiàn)。通常需要冷藏,保質(zhì)期短。使用減毒形式來模擬病毒如何鎖定細(xì)胞,將遺傳物質(zhì)注入其中。科學(xué)家們提取無害或減毒病毒的基因組,將來自其他微生物的部分遺傳物質(zhì)插入其中,然后將微生物DNA轉(zhuǎn)移到細(xì)胞中—這是一種良好的免疫刺激。 |
滅活苗/死苗 | 病原體可被熱、化學(xué)物質(zhì)或輻射殺死,因此它們無法回到致病狀態(tài)。大多數(shù)會引發(fā)較弱的免疫反應(yīng),可能需要加強(qiáng)免疫。 |
類毒素(滅活內(nèi)毒素) | 用于分泌毒素/化學(xué)物質(zhì)的細(xì)菌。毒素可以用甲醛溶液滅活。通過接種類毒素來訓(xùn)練機(jī)體對毒素做出反應(yīng)。 |
亞單位 · 結(jié)合 | 使用的是相關(guān)抗原,而不是整個病原體,降低了對疫苗產(chǎn)生不良反應(yīng)的機(jī)會。當(dāng)細(xì)菌由多糖外殼組成時可能是答案。這種涂層通過偽裝細(xì)菌抗原來躲避未成熟的免疫系統(tǒng)。這些疫苗通過與多糖結(jié)合的可識別抗原或類毒素來解決這一問題。 |
DNA | 是一類很有發(fā)展前景的疫苗。一旦對微生物的基因進(jìn)行了研究,科學(xué)家就可以制造出一種對抗微生物的DNA疫苗。設(shè)計和生產(chǎn)相對便宜,它們不需要機(jī)體的某些部分,而是向細(xì)胞提供制造抗原分子的指令,然后細(xì)胞分泌抗原,自己生產(chǎn)疫苗。 |
Nurmi和Rantala在1973年首次描述了競爭排斥原理,將有益細(xì)菌飼喂動物。這是非致病菌在腸道定植的地方,有助于控制有害細(xì)菌的數(shù)量。科學(xué)家們對種類繁多的細(xì)菌在動物胃腸道中的作用以及這種微生物群對人類和動物疾病的影響有了更多的了解。在畜牧業(yè),益生菌通過給動物飼喂細(xì)菌來發(fā)揮作用。該術(shù)語最早是由禮來公司和史迪威公司(1965)使用的,隨著時間的推移,該術(shù)語被改編和擴(kuò)大,指的是能夠給宿主帶來健康益處的微生物制劑。可以使用單一或多個菌株,也可以混合菌種,目前在家禽營養(yǎng)方面取得的進(jìn)展最多。
家禽飼養(yǎng)策略已經(jīng)改變以控制胃腸道微生物
這些菌株包括芽孢桿菌、大腸桿菌、乳酸菌、乳球菌、許多酵母菌和鏈球菌等。與此同時,益生元是不可消化的,被添加到飼料中,幫助細(xì)菌和有益微生物繁殖。兩者都“對非抗生素控制具有重大意義”。積極因素—腸道健康得到改善/維持,病原體定植被阻止,沒有停藥期。負(fù)面因素—單一益生菌復(fù)合物的混合功效需要監(jiān)管批準(zhǔn)。
中藥或植物源性產(chǎn)品是中國醫(yī)學(xué)重要的寶庫,幾千年的使用經(jīng)驗(yàn)證明,中藥具有強(qiáng)大的生命力,可以治療人類及動物的傳染或感染性疾病。機(jī)理—雖然中藥或植物源性產(chǎn)品對病毒或細(xì)菌的直接殺滅或抑制作用不是太強(qiáng),但通常是通過調(diào)理發(fā)揮機(jī)體自身抗病毒、抗菌能力,因此其特異性不強(qiáng)。積極的作用—中藥或植物源性產(chǎn)品具有提高機(jī)體抵抗力,從而清除病原體和減少排毒(菌),提高動物生產(chǎn)性能。由于不一定針對特定病原體,因而細(xì)菌產(chǎn)生耐藥性的機(jī)會比較小。負(fù)面作用—中藥可能會因?yàn)楫a(chǎn)地(道地藥材更好)、季節(jié)以及采收方法的不同而產(chǎn)生不同的療效;可能有農(nóng)藥等殘留,因?yàn)槟壳耙揽看罅糠N植才能滿足供應(yīng),經(jīng)常使用農(nóng)藥和化肥;標(biāo)準(zhǔn)難以建立,即真正有效的成分不一定是含量最高的。噬菌體是可感染細(xì)菌的病毒。噬菌體入侵細(xì)菌并破壞它們的新陳代謝,導(dǎo)致它們裂解(殺死這些細(xì)菌)。在東歐和俄羅斯的人類醫(yī)學(xué)中,噬菌體療法用于治療動物和植物中的食源性病原體。噬菌體療法的一個特點(diǎn)包括改造細(xì)菌以產(chǎn)生內(nèi)溶素和外溶素。這些酶通過破壞細(xì)菌的保護(hù)膜來分解細(xì)胞,保護(hù)膜決定了細(xì)菌的形態(tài)—肽聚糖壁。內(nèi)溶素作用于廣泛的靶標(biāo),通過在細(xì)胞內(nèi)部工作來殺死細(xì)胞,而外溶素則被分泌。外溶素由真核細(xì)胞分泌,一個例子是溶菌酶,一種在眼淚和唾液中發(fā)現(xiàn)的抗菌劑。它們通過破壞肽聚糖壁(細(xì)菌細(xì)胞的保護(hù)屏障)起作用,決定細(xì)菌形狀并作用于一系列目標(biāo)。積極作用—可以混合靶向特定噬菌體以減少耐藥性的發(fā)展。局部應(yīng)用被認(rèn)為是特別有效的,它們可以與抗生素一起使用。負(fù)面因素—可能會產(chǎn)生耐藥性。由于特異性,處理細(xì)菌亞種時可能遇到麻煩。

與噬菌體類似,細(xì)菌素通過聚焦于細(xì)胞質(zhì)膜來攻擊細(xì)菌。此外,它們被認(rèn)為比抗生素具有更低的耐藥性。幾乎所有的細(xì)菌都會分泌細(xì)菌素,并抑制相近物種的生長,這意味著有可能進(jìn)行廣泛的治療,其中許多可能是針對特定目標(biāo)的。其優(yōu)點(diǎn)包括抗紫外線和耐熱,與其他抗菌肽不同,它們對哺乳動物細(xì)胞沒有毒性。乳酸菌產(chǎn)生一種細(xì)菌素—乳酸鏈球菌素a,在50多個國家被用于食品保鮮,如在發(fā)酵奶酪和酸奶的乳制品中??茖W(xué)家說,盡管廣泛使用,很少有耐藥性的報道。捕食性細(xì)菌被認(rèn)為是一種非常規(guī)且有趣的抗生素替代品,它通過捕殺細(xì)菌來獲取營養(yǎng)和能量。有希望的是蛭弧菌和像BALO這樣的有機(jī)體,它們使用酶來殺死革蘭氏陰性細(xì)菌。它們以攻擊生物膜的方式而聞名,生物膜是作為一個有機(jī)體的細(xì)菌細(xì)胞層。這是一個主要的積極反應(yīng),因?yàn)樯锬ぜ?xì)菌對抗生素的抵抗力更強(qiáng)。
除了抗菌物質(zhì)的替代品,還有許多方法可以提高抗生素劑量以提高抗生素的功效,包括:聯(lián)合使用其他抗生素;用分子抑制耐藥基因和使用非抗生素增效。這些被稱為佐劑,近年來一個顯著的發(fā)展是一種佐劑,可以消除一些細(xì)菌對β-內(nèi)酰胺的耐藥性機(jī)制,β-內(nèi)酰胺是一類包括青霉素的抗生素,不斷有新一代產(chǎn)生。β-內(nèi)酰胺酶是細(xì)菌產(chǎn)生的酶,負(fù)責(zé)產(chǎn)生耐藥性。例如,當(dāng)給予青霉素類β-內(nèi)酰胺類藥物時,如阿莫西林配合克拉維酸。該酸通過抑制β-內(nèi)酰胺酶作為佐劑起作用。某些細(xì)菌通過稱為細(xì)菌外排泵的機(jī)制將藥物從其膜中泵出而產(chǎn)生耐藥性,有一些方法可以抑制細(xì)菌的這種耐藥機(jī)制。
并不是所有的細(xì)菌都能在像大腸桿菌這樣的培養(yǎng)皿中進(jìn)行研究。泰斯巴?。═eixobactin)是在實(shí)驗(yàn)室的適當(dāng)條件下發(fā)現(xiàn)的。已在動物和人類中分析了外排泵抑制劑。目的之一是找到一種這樣的針對雞食源性病原體空腸彎曲桿菌的抑制劑。同樣,實(shí)驗(yàn)也表明,噬菌體和細(xì)菌素可以增加抗生素的潛力。此外,目前可用的抗生素應(yīng)負(fù)責(zé)任地使用,這可以通過使用診斷檢測確保對感染使用正確的藥物,并確保患者按照臨床醫(yī)生的建議使用抗生素來實(shí)現(xiàn)。這些措施將有助于保護(hù)我們現(xiàn)有的抗生素及其組合。對一些最頑強(qiáng)的細(xì)菌菌株可能有一種新的處理方法,可以防止細(xì)菌形成外層,這意味著細(xì)菌很難獲得耐藥性,無論它經(jīng)歷了多少突變。美國東北大學(xué)的微生物學(xué)家收到了發(fā)現(xiàn)泰斯巴汀的全球報道。雖然對哺乳動物細(xì)胞無害,但它攻擊革蘭氏陽性病原體,如金黃色葡萄球菌、腸球菌和結(jié)核分枝桿菌。
此外,通過名為“芯片”的微型裝置創(chuàng)造理想的細(xì)菌環(huán)境的發(fā)現(xiàn)方法也值得注意。芯片可以在自然環(huán)境中分離并促進(jìn)單細(xì)胞的生長,這可能會讓科學(xué)家研究更多的微生物。
這可能是一條發(fā)現(xiàn)更多藥物的途徑。促進(jìn)非培養(yǎng)細(xì)菌生長讓科學(xué)家有機(jī)會分析更多未開發(fā)的微生物,在當(dāng)前的健康危機(jī)下,這可能非常有用。
免責(zé)聲明:本文部分內(nèi)容,來源于“Pig Progress”。我們尊重原創(chuàng),重在分享。